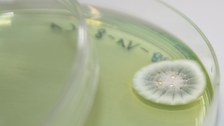
gewachsene Kolonie auf einer Agarplatte

Microbiology for Bioprocess Engineers
The lecture imparts basic knowledge in the field of microbiology with the emphasis on the role of microoganisms in the materials cycle of nature. The students will be shown modern techniques for production, characterisation, cultivation and maintenance of strains in biotechnical processes. The lecture contains the following topics:
- prokaryotes, viruses and eukaryotes
- molecular genetics of microorganisms
- metabolism, physiology und ecology
- contribution to materials cycle
- methods of colony counting
- selection and strain maintenance

© Schneider

© Schneider

© Schneider

© Schneider

© Schmidt

© Schneider
Workload and audience
- 4 weekly lecture hours lecture in winter and sommer semester
- additional 4 weekly lecture hours practical course in winter and sommer semester
- obligatory for bioprocess engineers
Recommended literature
- Alef K (1991) Handbuch Bodenmikrobiolgie, Lansberg: ecomed
- Schlegel H G (1992) Allgemeine Mikrobiologie, Stuttgart: Thieme
- Krippers R (1997) Molekulare Genetik, Stuttgart: Thieme
- Baumgart J (1990) Mikrobiologische Untersuchung von Lebensmitteln, Hamburg: Behr's
- David W (1975) Experimentelle Mikrobiologie, Heidelberg: Quelle & Meier
- Mudrack K (1994) Biologie der Abwasserreinigung, Stuttgart: Gustav Fischer
Lecturer
Contact for practical course:
 © Mann
© Mann
Scientist
NamePD Dr.-Ing. habil. Juliane Steingroewer
Head of Plant- and Algaebiotechnology
Send encrypted email via the SecureMail portal (for TUD external users only).